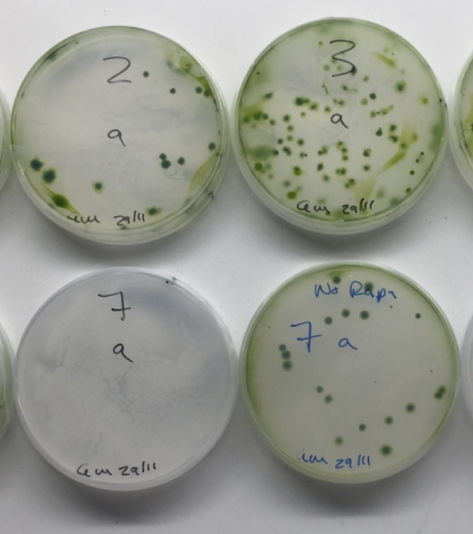

The Molecular Biology & Open Labware Training Workshop was developed to reach, teach and provide relevant academic resources to Africa-based agricultural researchers.
Read MoreTwo-ady workshop facilitating the adoption of “Speed Breeding” in East Africa.
Read MoreThis project aims to identify purification methods that can later be scaled up to develop cost-optimised protocols for distributed production of research enzymes.
Read MoreThe paper-based cell-free transcription-translation (TXTL) system should simplify studying gene circuitry.
Read MoreA synthetic biology approach to investigate the where and how receptor kinase signalling operates in arbuscular mycorrhizal (AM) symbiosis.
Read MoreOur aim is to generate genome-wide DNA hypomethylated wheat to study i) synthetic remodeling of meiotic recombination and ii) epigenetic control of wheat heterosis.
Read MoreWe aim to establish a CRISPR/Cpf1-based technique to insert transgenes into specific genome sites that are predicted to promote high expression.
Read MoreOur goal is to develop a new method that will facilitate the design of synthetic promoters with varying strength or specificity and will be a useful tool for genome engineering.
Read MoreThis project specifically aims to develop tags in Marchantia for localisation to the tonoplast (vacuole membrane), Golgi apparatus, oil bodies, peroxisome and mitochondria.
Read MoreBuild capacity and establish practical strategies and effective partnerships that can improve agricultural productivity and food security in sub-Saharan Africa.
Read MoreExploring emerging questions and discussions around the practice of synthesizing DNA in the context of global biological diversity use and regulation.
Read More